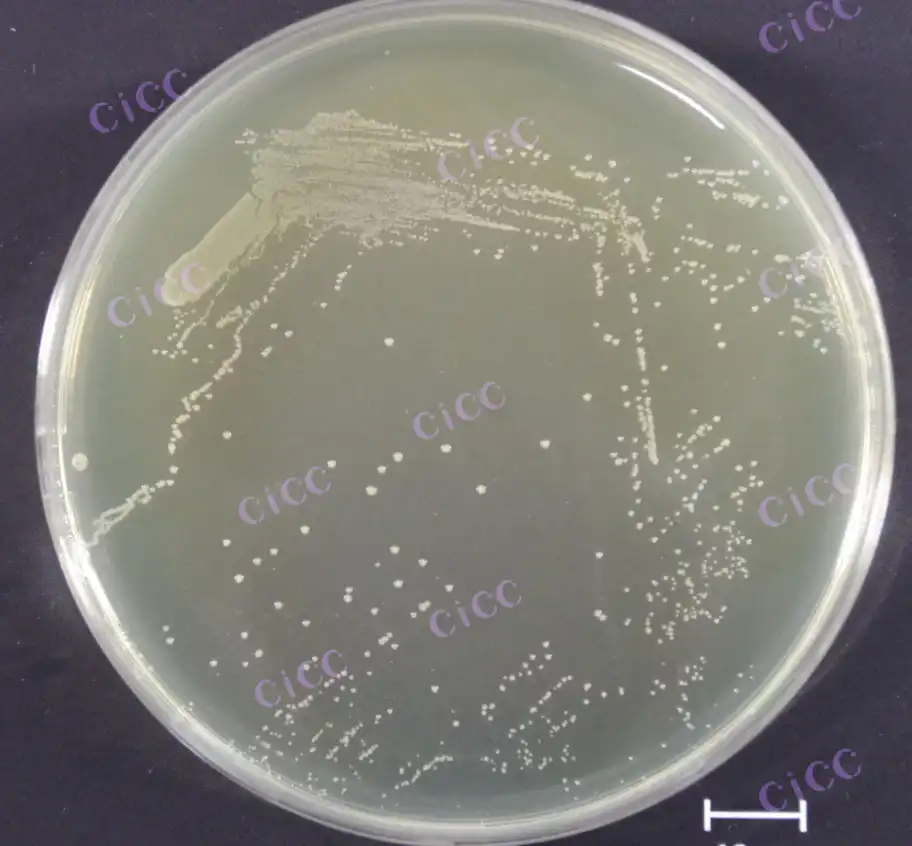
Akkermansia muciniphila as a Next-Gen Probiotic

Home >
2025-06-23 18:44:57
Can pregnant women take supplements containing Ganoderma lucidum Extract?
SHOW MORE2025-06-23 18:44:32
What evidence supports that Ganoderma lucidum Extract can lower blood sugar?
SHOW MORE2025-06-20 18:00:58
Are synergistic effects seen with Mulberry Yellow Extract combinations?
SHOW MORE
- 1
- 2
- 3
- 4
- 5
- 6
Total 6 pages

_1746003921546.webp)